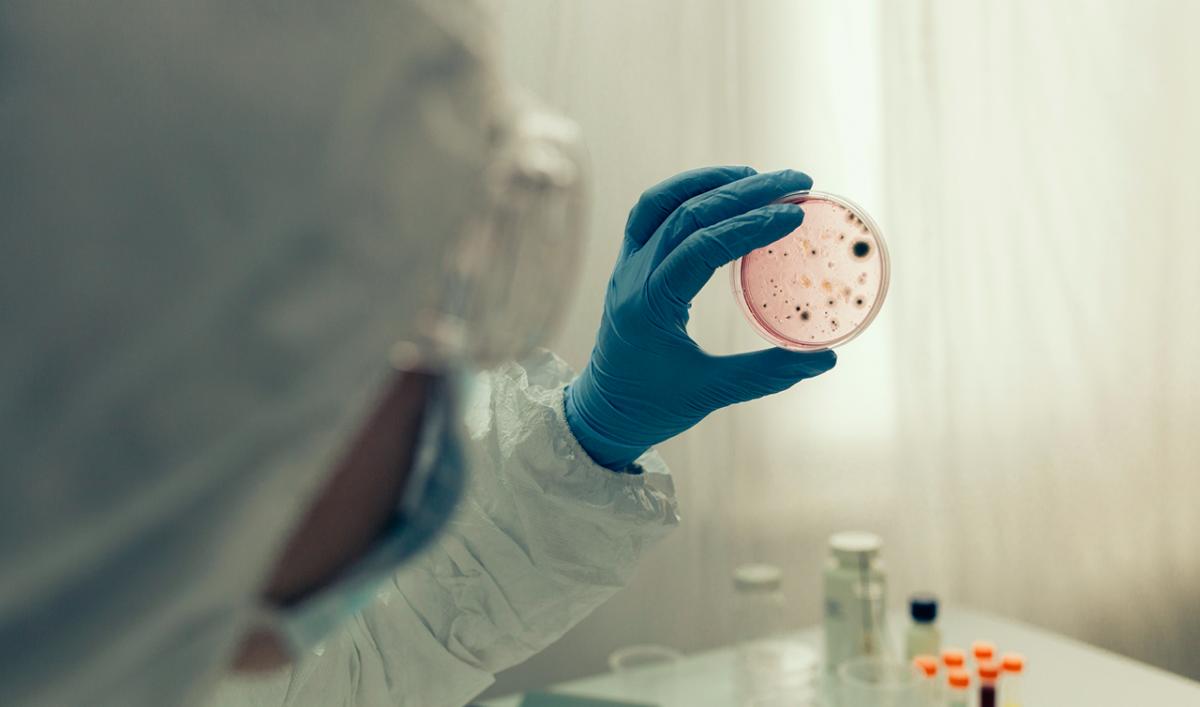

メガトレンド
メガトレンドが支えるピクテのテーマ株式投資
30年後、私たちの住む世界はどのようになっているのでしょう。
多くのロボットが働き、街を走るのは自動運転の電気自動車。
バイオ技術の進歩による遺伝子治療が普及し、新興国は大きな発展を遂げる。
そんな未来がぼんやりと見えてきたのではないでしょうか。
「メガトレンド」は未来を形作る長期トレンドであり、
ピクテのテーマ株式運用は、様々なメガトレンドの交差点で生まれます。

流行は追わない。求めるべき成長はメガトレンドに
流行は1年で終わり、トレンドも5~10年程度で変化を遂げていくものです。
我々が追い求めるのは10~15年の長期にわたり世界に影響を及ぼし続けるもの、未来を形作る「メガトレンド」です。
メガトレンドのイメージ
未来をつくる21のメガトレンド
メガトレンドには様々なものがありますが、ピクテはコペンハーゲン未来学研究所の助言を受け21の「メガトレンド」を策定。
それぞれが長期的な社会的需要や発展につながり、今後の世界を形作る長期トレンドです。
ピクテの策定するメガトレンド
メガトレンドが結びつき生まれる投資テーマ
ピクテのテーマ株式運用の投資テーマは複数のメガトレンドの交差点に生まれます。
「メガトレンドは持続的で影響力も大きい世界的な潮流であり、メガトレンドの交差点に投資テーマを重ねることで中長期的な成長を享受する。」
それが、ピクテが世界の富裕層に提供するテーマ株式運用の投資哲学です。
投資テーマ毎のメガトレンド例
各投資テーマの成長を捉えるために
各投資テーマの成長を支えるのは、メガトレンドに基づく市場の拡大や技術革新、投資環境の変化です。
メガトレンドを捉えることが、各投資テーマの成長ドライバーを捉えることに繋がるのです。
各投資テーマに関連する成長予測
5分で分かるメガトレンド
メガトレンドに基づく注目の投資テーマ
ROBOTICS
ロボティクスを生み出す潮流
物質化・非物質化/AIとコンピューティング・パワー/より大きな相互関連性/(脱)グローバル化/経済成長/サービス経済/専門家・複雑化
生産性向上、コスト削減、そして高齢化にともなう課題解決にも役立つロボティクス。
近年ロボットは経済効率、安全性の高まりから、様々な分野のサービス業・製造業に展開されています。たとえば医療分野ではロボットが腹腔鏡手術を外科医とともに担っています。ロボットの活躍にあわせ規制環境も変化、ドローンの商業利用も徐々に始まってきています。身近なところでは、ロボット掃除機の活躍もその一例です。

BIOTECH
バイオテックを生み出す潮流
AIとコンピューティング・パワー/ライフ・サイエンス/環境の質/ジェネレーション・シフト/経済成長/専門家・複雑化/健康への配慮/個別化と権利拡大
人口が増え続け、人間の寿命も延び続けている今、医療費を抑え、患者を病院から遠ざけるための新しい方法を見出す必要があります。
バイオ企業は、その生物学的プロセスを使って私たちの生活向上を目的とした医薬品、医療技術を開発することによって、このような課題を克服する極めて重要な役割を果たすことになります。
PREMIUM BRAND
プレミアム・ブランドを生み出す潮流
仮想化・非物質化/(脱)グローバル化/ジェネレーション・シフト/経済成長/サービス経済/格差の拡大/個別化と権利拡大
ブランド商品は、もはや先進国だけに留まらず、高い経済成長を背景に新興国の需要も高まっています。
また、プレミアム・ブランド企業は小売業界の中でも、消費者に幸福感、優越感などの感情をもたらすことができる商品・サービスを提供することで特別な地位にあり、世界中の裕福な顧客を引き付けています。

CLEAN ENERGY
クリーン・エネルギーを生み出す潮流
AIとコンピューティング・パワー/気候変動/資源不足/地政学的緊張/経済成長/健康への配慮
世界的なエネルギー需要の増加、そして環境汚染問題に対し、全世界が共同で対応する必要があるとの認識が高まり、政府、民間企業、そして個人も、低(もしくはゼロ)炭素燃料への移行を支持しています。
技術的な進歩によりクリーン・エネルギーの生産コストは低下、持続可能なクリーン・エネルギーへの移行は急速に進んでいます。BloombergNEFによれば、2050年までに世界のエネルギー生産量の50%が再生可能エネルギーになると予想されています。

SECURITY
セキュリティを生み出す潮流
物質化と非物質化/AIとコンピューティング・パワー/より大きな相互関連性/地政学的緊張/都市化/サービス経済/格差の拡大
私達が心身ともに豊かで快適に暮らすためには、日常の安心が不可欠です。
そんな私たちの「暮らしの安心」「移動の安心」「情報の安心」を支える製品やサービスの重要性は規制の強化、技術革新、新興国の都市化などにより、今後更に高まると予想されます。

TIMBER
ティンバーを生み出す潮流
新しい素材/環境の質/気候変動/資源不足/生物多様性・生態系サービス/都市化/経済成長
建築材料から、包装材、木材製品、紙製品まで、汎用性の高い素材である木材。
世界的な人口の増加や消費の拡大を背景に、需給はますます逼迫しています。持続可能な形での森林管理を行いながら、今後の需要を満たすための木材サプライチェーンを確保するために、さらなる投資が求められています。

SMARTCITY
スマートシティを生み出す潮流
仮想化・非物質化/より大きな相互関連性/資源不足/ジェネレーション・シフト/都市化
都市はイノベーションと繁栄の中心として国の経済成長を牽引しており、世界的に都市部への人口流入は加速しています。
一方、それに伴うインフラや天然資源の圧迫、温室効果ガスの排出による環境への影響などが懸念されており、未来の都市を持続可能な方法で建設、運営、管理していくために、新しい技術やサービスの開発が進められています。

メガトレンドに基づく投資戦略の開発プロセス
従来の投資戦略は、時価総額で構成される指数をベースに構築されます。これは企業の過去の成功に着目したものであり、今後の成長性を重視したものではありません。
一方、メガトレンドに基づく投資戦略は、世界が劇的に変化していく中で、将来成功すると思われる企業の成長ポテンシャルに注目し構築されます。
投資戦略の構築プロセス
運用チームは、各投資テーマの専門知識を持った実務家と研究者からなるアドバイザリー・ボードからの情報に基づく将来予測を、投資ユニバースに反映させます。
各投資テーマに関連する成長予測
お申込みにあたっては、交付目論見書等を必ずご確認の上、ご自身でご判断下さい。
投資リスク、手続き・手数料等については以下の各ファンド詳細ページの投資信託説明書(交付目論見書)をご確認ください。
ピクテ・グローバル・インカム株式ファンド(毎月分配型)
出所:ピクテ・アセット・マネジメント
当資料はピクテ・グループが作成した資料をピクテ・ジャパン株式会社が翻訳・編集したものです。
●当資料はピクテ・グループの海外拠点からの情報提供に基づき、ピクテ・ジャパン株式会社が翻訳・編集し、作成した資料であり、特定の商品の勧誘や売買の推奨等を目的としたものではなく、また特定の銘柄および市場の推奨やその価格動向を示唆するものでもありません。
●運用による損益は、すべて投資者の皆さまに帰属します。
●当資料に記載された過去の実績は、将来の成果等を示唆あるいは保証するものではありません。
●当資料は信頼できると考えられる情報に基づき作成されていますが、その正確性、完全性、使用目的への適合性を保証するものではありません。
●当資料中に示された情報等は、作成日現在のものであり、事前の連絡なしに変更されることがあります。
●投資信託は預金等ではなく元本および利回りの保証はありません。
●投資信託は、預金や保険契約と異なり、預金保険機構・保険契約者保護機構の保護の対象ではありません。
●登録金融機関でご購入いただいた投資信託は、投資者保護基金の対象とはなりません。
●当資料に掲載されているいかなる情報も、法務、会計、税務、経営、投資その他に係る助言を構成するものではありません。
手数料およびリスクについてはこちら
MSCI指数は、MSCIが開発した指数です。同指数に対する著作権、知的所有権その他一切の権利はMSCIに帰属します。またMSCIは、同指数の内容を変更する権利および公表を停止する権利を有しています。